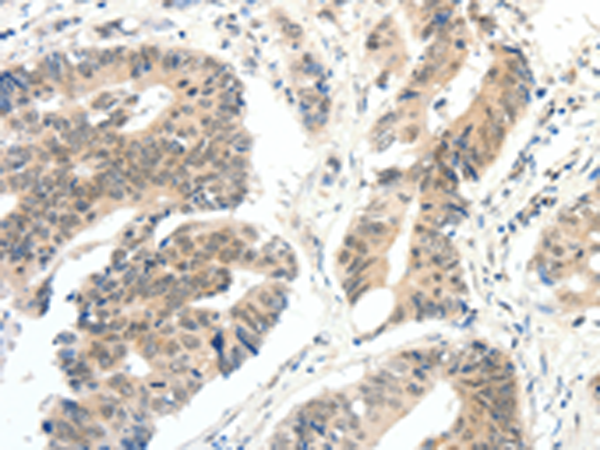
一抗

|
Background: |
This gene belongs to the FAM3 family.It may act as a defensin against invading fungal microorganisms.Mostly expression in testis, pancreas, adrenal, placenta, brain, fetal brain, liver, kidney, skeletal muscle and heart. |
|
Applications: |
ELISA, IHC |
|
Name of antibody: |
FAM3A |
|
Immunogen: |
Fusion protein of human FAM3A |
|
Full name: |
family with sequence similarity 3, member A |
|
Synonyms: |
DLD, 2.19, XAP-7, DXS560S |
|
SwissProt: |
P98173 |
|
ELISA Recommended dilution: |
1000-5000 |
|
IHC positive control: |
Human colon cancer |
|
IHC Recommend dilution: |
25-100 |

 購物車
購物車 幫助
幫助
 021-54845833/15800441009
021-54845833/15800441009